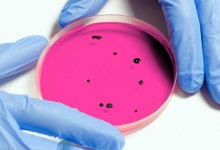

주식회사 YH바이오사이언스 총98명이 열람하였으며, 0개의 리뷰가 있습니다.
- 번호
- 78,920
- 개방서비스명
- 의료기기판매(임대)업
- 개방서비스아이디
- 01_02_03_P
- 개방자치단체코드
- 3,440,000
- 관리번호
- PHMG120223440024047000099
- 인허가일자
- 2015-03-24
- 영업상태구분코드
- 1
- 영업상태명
- 영업/정상
- 상세영업상태코드
- 13
- 상세영업상태명
- 영업중
- 소재지전체주소
- 대구광역시 남구 대명동 ****-**
- 도로명전체주소
- 대구광역시 남구 대명복개로 ***-*, *층 (대명동)
- 도로명우편번호
- 42,473
- 사업장명
- 주식회사 YH바이오사이언스
- 최종수정시점
- 2022-09-29 11:44:31
- 데이터갱신구분
- I
- 데이터갱신일자
- 2022-10-01 00:22:26
- 좌표정보x(epsg5174)
- 129
- 좌표정보y(epsg5174)
- 36
주변 목록
(주)코리아세븐 대구대명파크점
대구광역시 남구 대명동 ****-**
'주식회사 YH바이오사이언스'에서 0.1km
대구광역시 남구 대명동 ****-**
바로가기
플러스 메디칼
대구광역시 남구 대명동 ****-*
'주식회사 YH바이오사이언스'에서 0.1km
대구광역시 남구 대명동 ****-*
바로가기
효성의료기
대구광역시 남구 대명동 ****-*
'주식회사 YH바이오사이언스'에서 0.1km
대구광역시 남구 대명동 ****-*
바로가기
예지인 의료기기
대구광역시 남구 대명동 ****-*
'주식회사 YH바이오사이언스'에서 0.1km
대구광역시 남구 대명동 ****-*
바로가기
편 테라피
대구광역시 남구 대명동 ****-*
'주식회사 YH바이오사이언스'에서 0.2km
대구광역시 남구 대명동 ****-*
바로가기
대학의료기
대구광역시 남구 대명동 ****번지 *호
'주식회사 YH바이오사이언스'에서 0.2km
대구광역시 남구 대명동 ****번지 *호
바로가기
GS25대구남구원룸점
대구광역시 남구 대명동 ****-*
'주식회사 YH바이오사이언스'에서 0.2km
대구광역시 남구 대명동 ****-*
바로가기
다이소 대구안지랑점
대구광역시 남구 대명동 ****-*
'주식회사 YH바이오사이언스'에서 0.2km
대구광역시 남구 대명동 ****-*
바로가기
주변 의료기기 수리업
올림푸스한국(주) 대구사무소
대구광역시 남구 대명동 959-10
'주식회사 YH바이오사이언스'에서 0.35km
바로가기
랜드렉스대구지사
대구광역시 남구 대명동 1225번지 12호
'주식회사 YH바이오사이언스'에서 0.93km
바로가기
서비스월드
대구광역시 남구 대명11동 1468번지 11호
'주식회사 YH바이오사이언스'에서 1.07km
바로가기
대구장애인보장구수리센터
대구광역시 남구 대명동 2258번지 48호
'주식회사 YH바이오사이언스'에서 1.22km
바로가기
(주)남대구전자
대구광역시 달서구 성당동 261번지 4호
'주식회사 YH바이오사이언스'에서 1.32km
바로가기
(주)남북메디칼
대구광역시 남구 대명5동 318번지 4호
'주식회사 YH바이오사이언스'에서 1.48km
바로가기
(주)동우메디칼
대구광역시 남구 대명동 1583번지 1호
'주식회사 YH바이오사이언스'에서 1.49km
바로가기
주식회사 백년가게 국제의료기
대구광역시 달서구 두류동 776번지 15호
'주식회사 YH바이오사이언스'에서 1.66km
바로가기
계명메디케어
대구광역시 달서구 성당동 552-9
'주식회사 YH바이오사이언스'에서 1.67km
바로가기
영진메디컬
대구광역시 남구 대명동 1897-14
'주식회사 YH바이오사이언스'에서 1.72km
바로가기
(주)위블루씨엘
대구광역시 남구 대명동 2278-16
'주식회사 YH바이오사이언스'에서 1.92km
바로가기
(주)비앤티코리아
대구광역시 남구 대명동 2275-1
'주식회사 YH바이오사이언스'에서 1.97km
바로가기
주변 부속 의료기관
대구.경북 지방병무청(징병검사장)
대구광역시 달서구 죽전동 95번지 11호 징병검사장
'주식회사 YH바이오사이언스'에서 3.41km
바로가기
대구법원종합청사 부속의원
대구광역시 수성구 범어동
'주식회사 YH바이오사이언스'에서 5.81km
바로가기
경북대학교부속의원
'주식회사 YH바이오사이언스'에서 6.49km
바로가기
대구시행복진흥사회서비스원 희망마을 부속의원
대구광역시 달성군 화원읍 본리리 85
'주식회사 YH바이오사이언스'에서 6.81km
바로가기
계명대학교보건진료센터
대구광역시 달서구 신당동 1000번지 계명대학교성서캠퍼스
'주식회사 YH바이오사이언스'에서 7.41km
바로가기
대구구치소부속의원
대구광역시 수성구 만촌1동 768번지 1호
'주식회사 YH바이오사이언스'에서 8.16km
바로가기
법무부 대구소년원 부속의원
대구광역시 북구 읍내동 1214번지
'주식회사 YH바이오사이언스'에서 11.22km
바로가기
대구교도소 부속의원
대구광역시 달성군 하빈면 감문리 833-39
'주식회사 YH바이오사이언스'에서 14.02km
바로가기
중앙병역판정검사소
대구광역시 동구 신서동 1168 중앙병역판정검사소
'주식회사 YH바이오사이언스'에서 15.25km
바로가기
한국가스공사 부속한의원
'주식회사 YH바이오사이언스'에서 15.25km
바로가기
대구경북지방병무청
'주식회사 YH바이오사이언스'에서 15.34km
바로가기
엘지디스플레이(주)부속의원
'주식회사 YH바이오사이언스'에서 31.66km
바로가기
주변 의료 유사업
밝은세상안마원 대명역점
대구광역시 남구 대명동 1623번지 3호 5층
'주식회사 YH바이오사이언스'에서 0.54km
바로가기
탁안마원
대구광역시 달서구 두류동 472-11
'주식회사 YH바이오사이언스'에서 1.99km
바로가기
미소건강안마원
대구광역시 달서구 두류동 840번지 82호
'주식회사 YH바이오사이언스'에서 2.08km
바로가기
달구벌안마센터안마원
대구광역시 달서구 두류동 840번지 193호
'주식회사 YH바이오사이언스'에서 2.1km
바로가기
밝은세상안마원 감삼역점
대구광역시 서구 내당동 458-55
'주식회사 YH바이오사이언스'에서 2.4km
바로가기
명덕건강안마원
대구광역시 중구 남산동 2111-1
'주식회사 YH바이오사이언스'에서 2.44km
바로가기
형제바우처안마원
대구광역시 남구 봉덕동 617번지 8호 5층
'주식회사 YH바이오사이언스'에서 2.56km
바로가기
올바른안마원
대구광역시 중구 대신동 305-1 태왕아너스스카이 아파트
'주식회사 YH바이오사이언스'에서 2.7km
바로가기
송원지압안마원
대구광역시 달서구 본동 1149번지 1호
'주식회사 YH바이오사이언스'에서 2.82km
바로가기
성모지압안마원
대구광역시 달서구 송현동 1944-11
'주식회사 YH바이오사이언스'에서 2.92km
바로가기
건강지킴이안마원
대구광역시 남구 봉덕동 942번지 3호
'주식회사 YH바이오사이언스'에서 3.1km
바로가기
몸편한안마원
'주식회사 YH바이오사이언스'에서 3.19km
바로가기
주변 의료법인
의료법인 문성의료재단
대구광역시 남구 대명동 3037번지 36호
'주식회사 YH바이오사이언스'에서 0.74km
바로가기
의료법인 일민의료재단
대구광역시 달서구 송현동 56번지 2호
'주식회사 YH바이오사이언스'에서 1.75km
바로가기
의료법인 상보의료재단
대구광역시 달서구 두류동 148번지 1호
'주식회사 YH바이오사이언스'에서 1.99km
바로가기
의료법인 명문의료재단
대구광역시 달서구 두류동 470번지 5호
'주식회사 YH바이오사이언스'에서 2.05km
바로가기
의료법인 대덕의료재단
대구광역시 서구 내당동 947번지 7호
'주식회사 YH바이오사이언스'에서 2.59km
바로가기
의료법인 구의료재단
대구광역시 달서구 감삼동 139번지 2호
'주식회사 YH바이오사이언스'에서 2.74km
바로가기
의료법인 열경의료재단
대구광역시 달서구 본동 1144번지
'주식회사 YH바이오사이언스'에서 2.92km
바로가기
의료법인 용각의료재단
대구광역시 서구 평리동 1097번지 1호
'주식회사 YH바이오사이언스'에서 3.33km
바로가기
의료법인 대명의료재단
대구광역시 서구 평리동 1421번지 5호
'주식회사 YH바이오사이언스'에서 3.43km
바로가기
의료법인 하나시아 의료재단
대구광역시 중구 봉산동 195번지 2호
'주식회사 YH바이오사이언스'에서 3.46km
바로가기
의료법인 운경의료재단
대구광역시 중구 수동 18번지
'주식회사 YH바이오사이언스'에서 3.6km
바로가기
의료법인 해정의료재단
대구광역시 수성구 수성동3가 327번지
'주식회사 YH바이오사이언스'에서 4.59km
바로가기
주변 병원
통합의료진흥원 전인병원
대구광역시 남구 대명동 986번지 4호
'주식회사 YH바이오사이언스'에서 0.17km
바로가기
대구가톨릭대학교병원
대구광역시 남구 대명4동 3056번지 6호
'주식회사 YH바이오사이언스'에서 0.29km
바로가기
대명휴요양병원
'주식회사 YH바이오사이언스'에서 0.44km
바로가기
문성병원
'주식회사 YH바이오사이언스'에서 0.74km
바로가기
성심요양병원
'주식회사 YH바이오사이언스'에서 1.1km
바로가기
휴요양병원
대구광역시 달서구 두류동 807번지 5호
'주식회사 YH바이오사이언스'에서 1.11km
바로가기
한결요양병원
'주식회사 YH바이오사이언스'에서 1.13km
바로가기
앞산요양병원
'주식회사 YH바이오사이언스'에서 1.14km
바로가기
대구명성요양병원
대구광역시 달서구 두류동 807번지 3호
'주식회사 YH바이오사이언스'에서 1.17km
바로가기
대구굿모닝병원
'주식회사 YH바이오사이언스'에서 1.26km
바로가기
곽치과병원
'주식회사 YH바이오사이언스'에서 1.27km
바로가기
대구요양병원
'주식회사 YH바이오사이언스'에서 1.28km
바로가기
블로그 리뷰
-
바이오사이언스, 백광산업, CJ제일제당 바이오 R&D 부문까지 각 기업별 분야별 자소서, 면접 코칭 가능합니다. 대상 AI역량검사 대상그룹은 서류 적부 평가로...전형이 포함되어 있습니다. 실제 합격하신 지원자 후기 대상(주) 식품사업 면접 후기, R&D 식품연구 채용공고 누적 컨설팅 6,000회 이상 식품 R&D 산업...
현대자동차 전문 면접 컨설팅(2026-04-20 14:01:00)

-
기고→ 사이언스21 2... 2026-01-13 2025년, 케이랩과 함께해 주셔서 감사합.... klabkis.com 실험실 장비 및 연구용 소모품을 공급하는 국내 유통 기업으로...장비를 글로벌로 공급합니다. 삼우에스엔티 주식회사 삼우에스앤티 삼우에스앤티,samwoosnt,주식회사 삼우에스앤티,merck,머크,labwater,1차수 제조장치,2...
시약의 기준을 정하다!(2026-04-02 15:08:00)

-
통해 '주식회사 페니트리움바이오사이언스'로 사명 변경을 결정했습니다. 이는 단순 CRO 역할을 넘어서 자체 신약 개발 및 파이프라인 확대 전략을 강조하는 중대한 구조 변화입니다. ● CRO 사업에서 벗어나 핵심 물질인 '페니트리움(Penetrium)' 연구 성과를 기반으로, 암 및 자가면역질환 등 치료제 임상 확대 의지를...
너의 뇌리에 가쿠인(2026-02-24 08:52:00)

-
집념, 사이언스 중심, 꾸준한 학회 발표가 바탕이 됐답니다. 📰 관련 기사 4: AD/PD 학회 발표 "에이비엘바이오 '파트너사 사노피, ABL301 비임상 결과 발표'" (출처: 서울경제, 2025년 4월 8일) AD/PD는 퇴행성 뇌질환 분야의 세계 최대 규모 학회로, 2025년 4월 1일부터 5일까지 오스트리아 비엔나에서 개최됐어요. ABL...
대백과주식(2026-02-01 16:43:00)

-
사이언스 주식회사의 현재 대표이사는 천종식님입니다. 정식 회사명은 씨제이바이오사이언스(주)이며, 영문명은 CJ Bioscience입니다. 사업자등록번호는 1198623145이고, 본사 주소는 서울특별시 중구 세종대로 14 그랜드센트럴타워 B동 7층에 위치해 있습니다. 설립일은 2009.11.18로, 연/월/일(YYYY/MM/DD) 형식으로...
Review or not(2025-07-18 02:51:57)

-
콥데이 후기, 승기를 잡다 2025-12-04 | 신한증권 [토모큐브] 토모큐브; 오가노이드, 어차피 토모큐브로 간다 2025-12-04 | 신한증권 [금호석유화학] 금호석유화학; 관심을 모아가야 할 때 2025-12-05 | 신한증권 [엘케이켐] 엘케이켐; AI반도체 '필수 비타민' 소재기업 2025-12-05 | 신한증권 [알테오젠 ] 알테오젠...
주식뉴스(2025-12-08 18:38:35)

-
통해 싸이언스 랩스에 500만 달러를 투자하여 주당 1,724달러의 공정 가치로 2,900개의 싸이랩스 주식을 취득하고, 4.36달러의 VWAP를 기준으로 115만 개의 PBM 주식과 교환함으로써 실로시빈과 이보가인 프로그램이 임상 및 상업 규모로 발전함에 따라 수직 통합을 강화하고 장기적으로 제약 등급의 환각제 공급을 강화...
운좋은투자자(淵 植 (연 식))(2026-02-24 22:54:00)

-
트렌드 바이오기업 오가노이드사이언스 기업 로고의 아이덴티티 작업은 오가노이드의 개념과 컨셉에서부터 시작됩니다. 한 개인의 특정 장기의 세포로 부터 시작하여 그 장기의 기능과 구조를 모사하는 특징을 시각적으로 표현했는데요. 유기적 형태의 인체 장기를 의미하고 점차적으로 분열하고 성장을 하는...
라우드소싱 공식 블로그(2025-12-04 17:36:00)

-
㈜YH데이타베이스 일만백만 ㈜컴퓨터메이트 ㈜타임시스템 ㈜아이지아이에스 ㈜비젼사이언스 한국카드시스템㈜ 주식회사이에이지 ㈜한맥아이피에스 코리아와이드아이티에스 ㈜한국알파시스템 ㈜범일정보 ㈜군월드 ㈜네오티시스 💼 모집직종 📌 실제 현업 담당자와의 만남을 통해 기업에 대한 깊은 이해와 실질적인 취업...
SW개발&DB 전문교육기관 예담직업전문학교(2025-09-17 16:14:00)

-
즉 후기 임상을 제외한 신약개발 전주기에 걸친 추진 및 협력 체계를 구축하고 있습니다. 주요 파이프라인으로는 고형암 치료제 AST-201, 면역항암제/ 혈액암 치료제 AST-202, 고형암 치료제 AST-203 등이 있습니다. 압타머사이언스 일봉 주가 차트(출처: 키움증권 영웅문) 📰 뉴스 이슈 정리 치매 치료제 개발업체...
라주연: 라치오주식연구소. AI로 쉽게 배우는 주식.(2025-07-03 10:02:00)

일별 방문 통계
월별 방문 통계
날씨
리뷰 (0)
등록된 리뷰가 없습니다.
첨부파일

![[주식회사에이비씨바이오사이언스] 영업 마케팅 프로젝트관리 담당자 채용 [ABC바이오사이언스] - 사람인](https://search.pstatic.net/sunny/?type=b150&src=https%3A%2F%2Fwww.cnrres.com%2Fwp-content%2Fuploads%2Fkboard_attached%2F1%2F202207%2F62e0d1b66444c8937503.png)
![[어스바이오] YSI 전문 수입 및 통관 | 연구용제품 > Bio마켓 | BRIC](https://search.pstatic.net/sunny/?type=b150&src=https%3A%2F%2Fwww.ibric.org%2Fupload%2Fgeditor%2F202209%2F0.31210300_1662350736.jpg)

![[웨비나] 바이오의약품 생산을 위한 세포주 맞춤형 배지 최적화 전략 | 행사 > Bio일정 | BRIC](https://search.pstatic.net/sunny/?type=b150&src=https%3A%2F%2Fbms.kr%2Fchayon_email%2Femail2025%2F251203_ajinomoto-webinar%2Fimages%2F251203_ajinomoto-webinar_01.jpg)
![[BioXCell한국대리점]Antibodies for IMMUNOLOGY Research | 연구용제품 > Bio마켓 | BRIC](https://search.pstatic.net/sunny/?type=b150&src=https%3A%2F%2Fwww.ibric.org%2Fupload%2Fgeditor%2F201910%2F0.01527700_1570422968.jpg)
![[PLAS LABS] CP Series | 연구용제품 > Bio마켓 | BRIC](https://search.pstatic.net/sunny/?type=b150&src=https%3A%2F%2Fwww.ibric.org%2Fupload%2Fgeditor%2F202207%2F0.12510500_1658191389.png)
![[AbClon] Monoclonal antibody development service | 연구용제품 > Bio마켓 | BRIC](https://search.pstatic.net/sunny/?type=b150&src=https%3A%2F%2Fwww.ibric.org%2Fupload%2Fgeditor%2F201307%2F0.35602700_1373967569.jpg)




![[Epigentek] Epigenteks Top Seller Product를 확인해보세요 ! | 연구용제품 > Bio마켓 | BRIC](https://search.pstatic.net/sunny/?type=b150&src=https%3A%2F%2Fwww.ibric.org%2F_attach%2Fbric%2Feditor-image%2F2025%2F12%2FCSKTPCNesatsBizCbExHyPiVaB.png)
![[GenScript] One Stop Solutions for GST-Tag | 연구용제품 > Bio마켓 | BRIC](https://search.pstatic.net/sunny/?type=b150&src=https%3A%2F%2Fwww.ibric.org%2Fupload%2Fgeditor%2F201310%2F0.14124300_1380600632.jpg)
![[전문상담] Spheroid/Organoid 배양부터 이미징까지, 하나의 플레이트로 효율적으로. | 연구용제품 > Bio마켓 | BRIC](https://search.pstatic.net/sunny/?type=b150&src=https%3A%2F%2Fbms.kr%2Fchayon_email%2Femail2025%2F250710_insphero%2Fimages%2F250710_insphero_02.jpg)
![[BioIVT]PBMC, 더 이상 힘들게 분리하지 마세요!-LEUKOMAX Leukopak | 연구용제품 > Bio마켓 | BRIC [BioIVT]PBMC, 더 이상 힘들게...](https://search.pstatic.net/sunny/?type=b150&src=https%3A%2F%2Fwww.ibric.org%2F_attach%2Fbric%2Feditor-image%2F2025%2F03%2FiypxxGbmuVXTLvVMaUhzGwOpsU.jpg)
![[MP Bio] 배지, 항생제, 전기 영동, 단백질 연구 관련 필수 바이오케미컬이 한 자리에! | 할인행사 > Bio마켓 | BRIC](https://search.pstatic.net/sunny/?type=b150&src=https%3A%2F%2Fwww.ibric.org%2F_attach%2Fbric%2Feditor-image%2F2025%2F08%2FZnxEUEXiOtPpRKfsxXeSRMGZtk.png)
![[샘플신청] CHO 세포 배양 성능을 향상시킬 새로운 솔루션 2가지를 경험해 보세요. [CELLiST BASAL CHO MX / F7] | 연구용제품 > Bio마켓...](https://search.pstatic.net/sunny/?type=b150&src=https%3A%2F%2Fchayon.co.kr%2Femail%2F2024%2F240227_ajinomoto%2Fimages%2F240227_ajinomoto_02.jpg)
![[배지 성분 분석기] At-line spent media analysis is now a reality | 연구용제품 > Bio마켓 | BRIC](https://search.pstatic.net/sunny/?type=b150&src=https%3A%2F%2Fwww.ibric.org%2Fupload%2Fboard%2Ffiles%2Fnew_protech%2Fnew_8%2Fphoto_0333618.jpg)
![[Epigentek] Sample Preparation for Epigenetoc Studies | 연구용제품 > Bio마켓 | BRIC](https://search.pstatic.net/sunny/?type=b150&src=https%3A%2F%2Fwww.ibric.org%2F_attach%2Fbric%2Feditor-image%2F2024%2F01%2FizZKjfnDMphZleobgTHhKwepTc.png)

![[Bioss 한국대리점] Antibodies for ALS Research | 연구용제품 > Bio마켓 | BRIC](https://search.pstatic.net/sunny/?type=b150&src=https%3A%2F%2Fwww.ibric.org%2Fupload%2Fgeditor%2F201905%2Fe28ad183c57494cea11b5b8eee25488a_1557293254_5632.png)
![[Greiner Bio-One]Cell Culture 필수품! Made In Germany! 고퀄리티의 그라이너 제품으로 세포배양하세요 : ) | 연구용제품 > Bio마켓...](https://search.pstatic.net/sunny/?type=b150&src=https%3A%2F%2Fwww.ibric.org%2Fupload%2Fgeditor%2F202301%2F0.11495800_1674624292.png)
![[Zymo Research] Microbiome Solution II | 연구용제품 > Bio마켓 | BRIC](https://search.pstatic.net/sunny/?type=b150&src=https%3A%2F%2Fwww.ibric.org%2Fupload%2Fgeditor%2F202205%2F0.61338000_1653887510.jpg)
![[R&D Systems] Antibody Validation, 이제 Bio-Techne가 기준입니다 | 연구용제품 > Bio마켓 | BRIC](https://search.pstatic.net/sunny/?type=b150&src=https%3A%2F%2Finfo.bio-techne.com%2Frs%2F584-XSF-168%2Fimages%2Fabval-email-hero-v3.png)



![주식회사 YH바이오사이언스 | [상한가 찍먹 종목 분석 7월 3일] 압타머사이언스, THE E&M, 코오롱모빌리티그룹우, 삼륭물산, 로킷헬스...](https://search1.kakaocdn.net/argon/130x130_85_c/IwEhhqmv0eg)